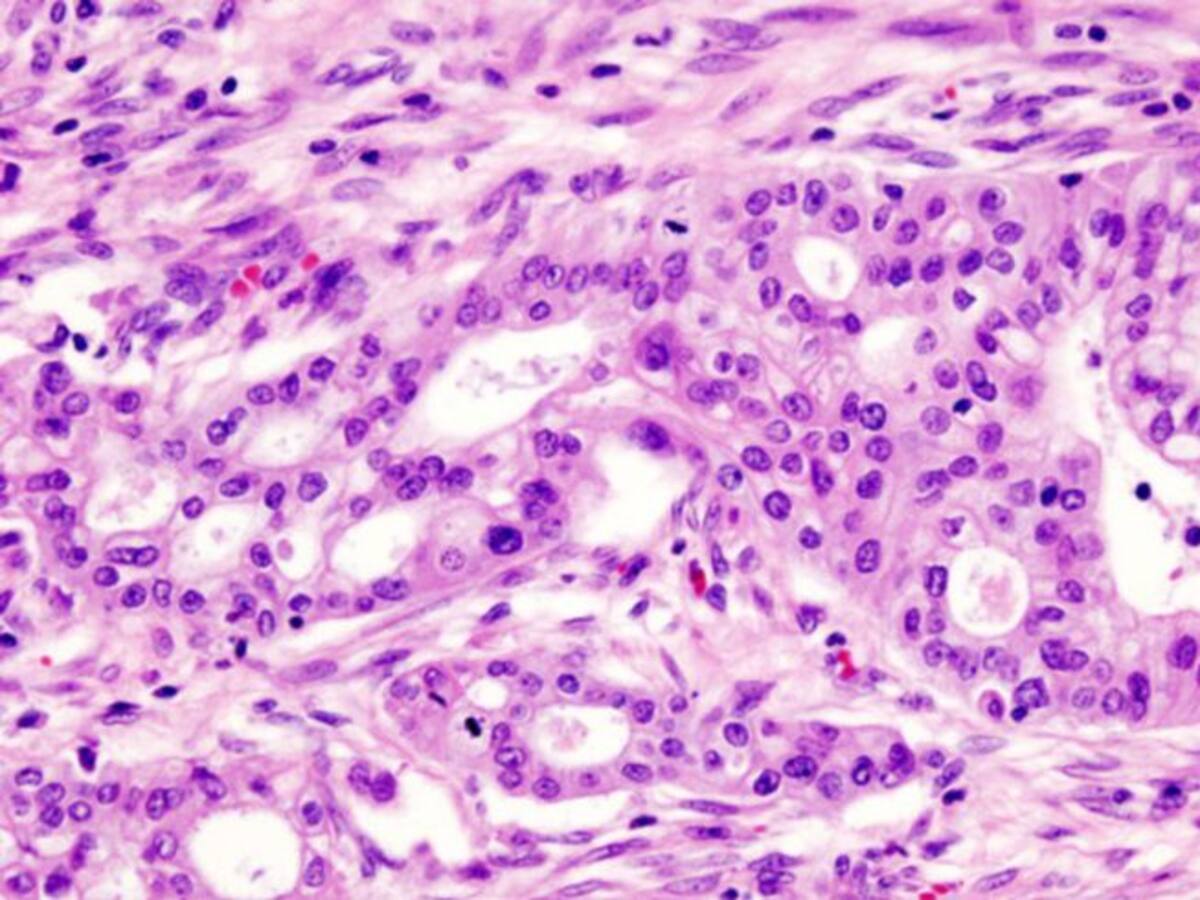

Luchar jugando
Paseando por la red encontramos el último spot de Juegaterapia, una denuncia contra el sistema de becas y otra denuncia. Esta, contra el maltrato de animales en espectáculos
03/06/2015 - 04:46
Talía Estévez
Madrid
Selecciona tu emisora

Paseando por la red encontramos el último spot de Juegaterapia, una denuncia contra el sistema de becas y otra denuncia. Esta, contra el maltrato de animales en espectáculos
03/06/2015 - 04:46
Talía Estévez
Madrid

30/05/2015 - 15:58
Valentina Rojo Squadroni
Madrid

26/05/2015 - 17:23
ACN
Barcelona

26/05/2015 - 17:01
Javier Bañuelos
Madrid

26/05/2015 - 16:05
Begoña Ávila
Santa Cruz de Tenerife

21/05/2015 - 05:11
Elena Sánchez
Madrid

19/05/2015 - 10:25
Jordi Guardiola
Barcelona

17/05/2015 - 10:18
Javier Bañuelos
Madrid

16/05/2015 - 15:10
Míriam F. Mata
Madrid

15/05/2015 - 11:17
Pilar García Atienza
Zaragoza

13/05/2015 - 17:08
Carlos G. Cano
Madrid

13/05/2015 - 13:25
Javier Gregori
Madrid

12/05/2015 - 15:58
Ana Rodríguez

11/05/2015 - 16:41
Paloma Monreal
Madrid

05/05/2015 - 12:34
EFE
Madrid

27/04/2015 - 12:43
Anna Puigboltas
Barcelona

27/04/2015 - 09:06
Inma Sánchez-Morate
Toledo

26/04/2015 - 16:26
Redacción

25/04/2015 - 11:48
Sonsoles Ferrín Soria
Andalucía
15/04/2015 - 13:35
Jordi Guardiola
Barcelona

15/04/2015 - 12:13
María Luisa García
Irun

14/04/2015 - 17:29
Javier Gregori
Madrid

13/04/2015 - 10:24
Sergi López
Barcelona

08/04/2015 - 19:43
Javier Cuevas
Valladolid

06/04/2015 - 15:18
Javier Gregori
Madrid

02/04/2015 - 14:32
Redacción
Málaga

24/03/2015 - 14:57
Redacción
Madrid

18/03/2015 - 10:48
Isabel León
Bilbao

11/03/2015 - 13:58
Jordi Guardiola
Barcelona

07/03/2015 - 10:19
Javier Bañuelos
Madrid

06/03/2015 - 14:56
Redacción
Madrid

06/03/2015 - 13:33
Redacción

23/02/2015 - 15:44
David Yurre
Vitoria

23/02/2015 - 01:22
Redacción

19/02/2015 - 17:08
Jesús Arroyo
Madrid

18/02/2015 - 07:03
Redacción
Madrid

15/02/2015 - 15:29
Sara Cuesta Torrado
Madrid

15/02/2015 - 15:18
Patricia Rey
Madrid

15/02/2015 - 12:30
Aloña Velasco
Bilbao

12/02/2015 - 17:17
Victoria García
Madrid
Ahora en directo
Cadena SER
00:00 - 23:59
00:00 - 23:59
Otros directosCadena SER
00:00 - 23:59
Podcast
Síguenos en
Otros episodios
Cualquier tiempo pasado fue anterior
Tu audio se ha acabado.
Te redirigiremos al directo.
5 "